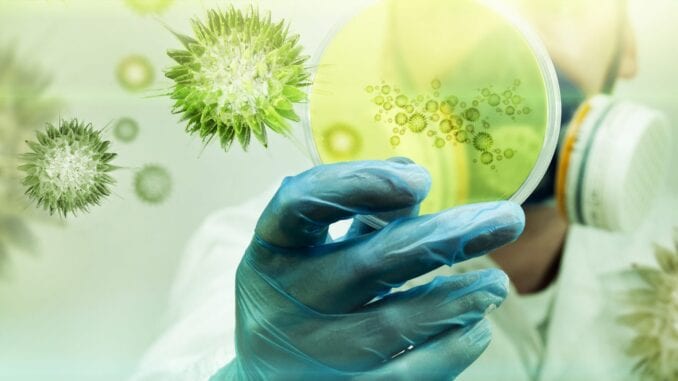
segunda cepa

Las autoridades de salud de Florida reportaron el jueves haber hallado evidencia del caso más reciente en Estados Unidos de la nueva y aparentemente más contagiosa variante del coronavirus vista por primera vez en Inglaterra, diciendo que fue detectada en un hombre que no ha viajado últimamente.
El caso, dado a conocer en un comunicado del Departamento de Salud de Florida tuiteado en su sitio web HealthyFla, fue detectado después de reportes en los últimos días de dos casos individuales de la variante de Gran Bretaña de COVID-19 descubiertos en Colorado y California.
En el comunicado, las autoridades de Florida indicaron que la nueva variante del virus fue detectada en un hombre de unos veintitantos años en el condado Martin, que limita con la costa del Atlántico al norte del densamente poblado sur de la península. El departamento de salud no dio más detalles, como por ejemplo el estado de salud del hombre o cómo se detectó la variante.
California anunció el miércoles el segundo caso confirmado en la nación de la nueva variante del coronavirus, 24 horas después de que se supiera de la primera infección con la variante en Estados Unidos, en Colorado. Se trató de un efectivo de la Guardia Nacional de ese estado que había sido enviado a ayudar a un asilo con problemas por un brote.
Los científicos en Gran Bretaña creen que la variante es más contagiosa que las cepas identificadas previamente. Los casos han generado interrogantes sobre cómo fue que la versión que está circulando en Inglaterra llegó a Estados Unidos, y si ya es demasiado tarde para detenerla. Algunos expertos dicen que probablemente ya se está propagando por el país. FUENTE: Con información de AP





